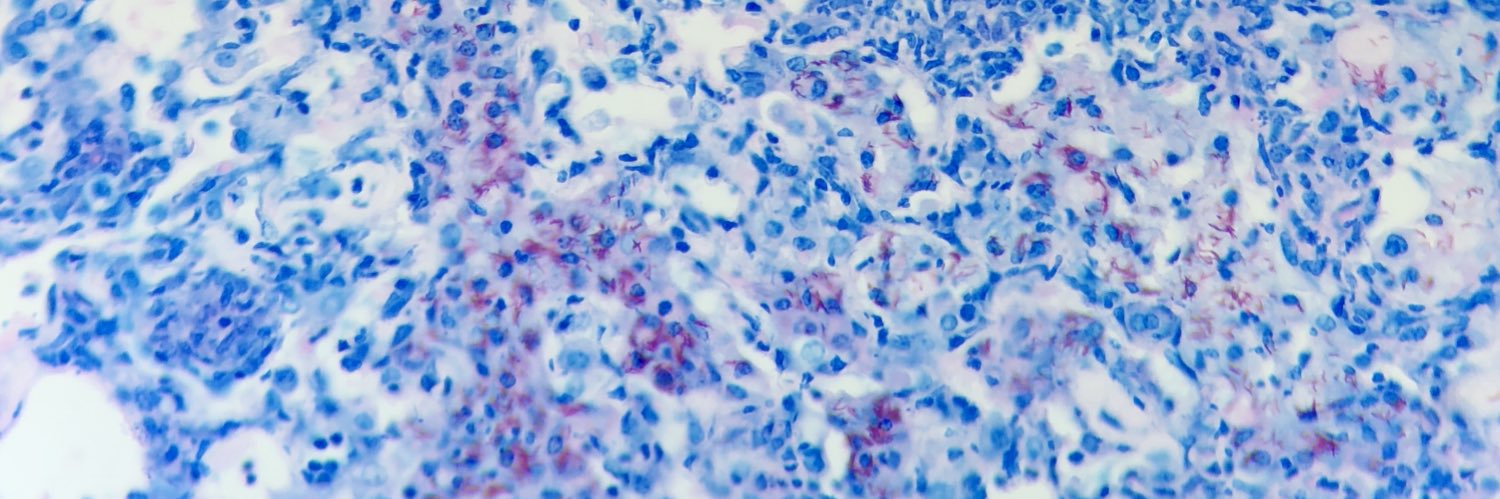
Daniel Barber, PhD banner

Daniel Barber, PhD retweetledi

In @elife: Selective JAK Inhibition Reveals Paradoxical and Hierarchical Control of interferon-γ-driven Autoimmunity in AIRE Deficiency doi.org/10.7554/eLife.…
Català
Daniel Barber, PhD
136 posts

@danielleobarber
Immunologist at the NIH/NIAID/Intramural Research Program.

















1/n Proud to share our latest work @NEJM. A long journey of integrated basic research and clinical care revealed a central role for IFN-g in driving mulitorgan autoimmunity in APECED and devised a personalized, life-transformative intervention for patients nejm.org/doi/full/10.10…


We are thrilled to announce the election of 120 members and 24 international members to the National Academy of Sciences in recognition of their distinguished and continued achievements in original research. Congratulations to our new #NASmembers and welcome to the Academy!

